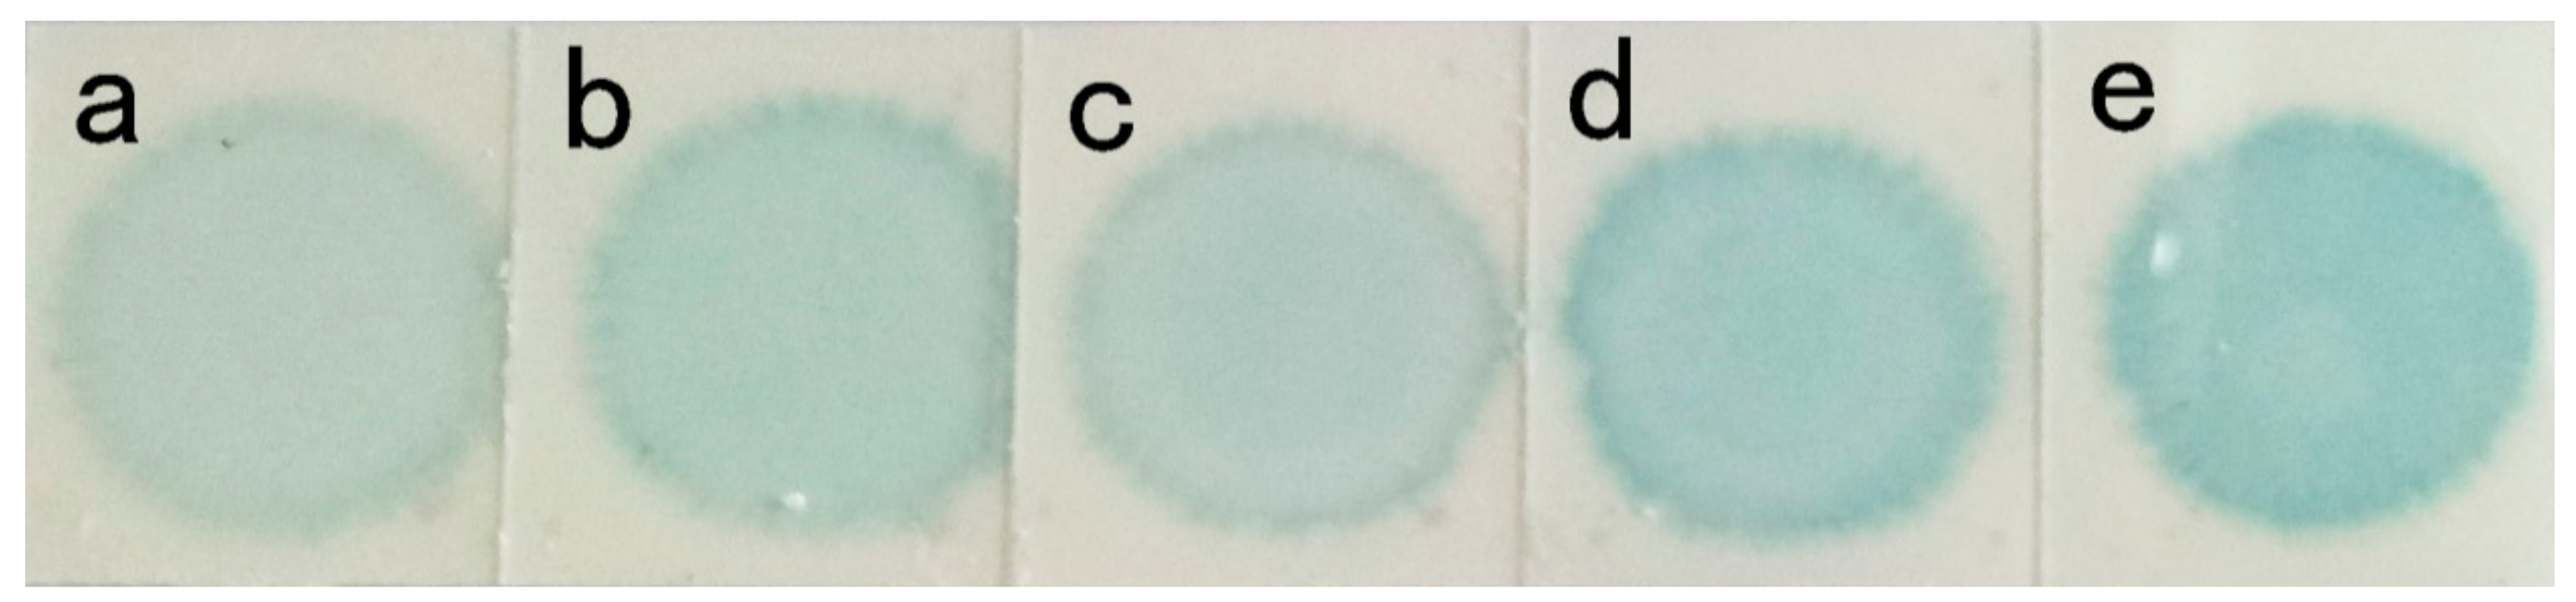
Crystals 08 00333 g011 Crystals 08 00333 g011

Formation and Application of High Reflectivity Controllable Barium Sulfate Microspheres
Abstract
1. Introduction
2. Materials and Methods
2.1. Materials
2.2. Methods
3. Results
3.1. Preparation of Barium Sulfate Microspheres
3.1.1. Influence of EDTA
3.1.2. Influence of Stirring Rate
3.1.3. Influence of Temperature Reflex
3.1.4. Influence of Ripening Time
3.2. Application
3.2.1. BaSO4 Multifunctional Layer
3.2.2. High-Density Lipoprotein Tablets
(a) Reproducibility
(b) Sensitivity
4. Conclusions
Author Contributions
Funding
Conflicts of Interest
References
- Nagaraja, B.M.; Jung, K.D.; Ahn, B.S. Catalytic decomposition of SO3 over Pt/BaSO4 materials in sulfur-iodine cycle for hydrogen production. Ind. Eng. Chem. Res. 2009, 48, 1451–1457. [Google Scholar] [CrossRef]
- Gao, H.W.; Lin, J.; Li, W.Y. Formation of shaped barium sulfate-dye hybrids: Waste dye utilization for eco-friendly treatment of wastewater. Environ. Sci. Pollut. Res. 2010, 17, 78–83. [Google Scholar] [CrossRef] [PubMed]
- O’Connor, S.D.; Yao, J.; Summers, R.M. Lytic metastases in thoracolumbar spine: Computer-aided detection at CT-preliminary study. Radiology 2007, 242, 811–816. [Google Scholar] [CrossRef] [PubMed]
- Yao, C.; Yang, G. Synthesis, thermal, and rheological properties of poly (trimethylene terephthalate)/BaSO4 nanocomposites. Polym. Adv. Technol. 2009, 20, 768–774. [Google Scholar] [CrossRef]
- Ricker, A.; Liu-Snyder, P.; Webster, T.J. The influence of nano MgO and BaSO4 particle size additives on properties of PMMA bone cement. Int. J. Nanomed. 2008, 3, 125. [Google Scholar]
- Romero-Ibarra, I.C.; Rodriguez, G.G.; Garcia-Sanchez, M.F. Hierarchically nanostructured barium sulfate fibers. Langmuir 2010, 26, 6954–6959. [Google Scholar] [CrossRef] [PubMed]
- Li, M.; Colfen, H.; Mann, S.J. Crystal design of Barium Sulfate using double-hydrophilic block copolymers. Angew. Chem. Int. Ed. Engl. 2000, 39, 604–607. [Google Scholar]
- Hua, L.N.; Wang, G.X.; Cao, R. Fabrication and surface properties of hydrophobic barium sulfate aggregates based on sodium cocoate modification. Appl. Surf. Sci. 2014, 315, 184–189. [Google Scholar] [CrossRef]
- Barium Sulfate. Available online: https://baike.so.com/doc/876966-7117269.html (accessed on 25 July 2018).
- Gu, X.Y. Preliminary Study on Characteristics of Structure of Voids in Particle Assemblies Generated by PFC3D. Master’s Thesis, Tsinghua University, Beijing, China, June 2009. [Google Scholar]
- Shi, H.M. Research on Permeability Characteristic of Porous Media of Pellets Packing. Master’s Thesis, Northeastern University, Shenyang, China, June 2005. [Google Scholar]
- Han, L.M. Development of ultra-fine barium sulfate. Inorg. Salt Ind. 1993, 2, 29. [Google Scholar]
- Li, J.; Liu, D.D. Effects of polyacrylic acid additive on barium sulfate particle morphology. Mater. Chem. Phys. 2016, 175, 180–187. [Google Scholar] [CrossRef]
- Wang, M.; Wang, Y.J. Preparation of ultrafine barium sulfate particle using a water/oil microemulsion. J. Tsinghua Univ. (Sci. Technol.) 2002, 42, 1594–1597. [Google Scholar]
- Liu, Y.Z.; Li, J.P. Preparation of barium sulfate nanoparticles. J. Basic Sci. Eng. 2001, 9, 2–3. [Google Scholar]
- Uchida, M.; Sue, A.; Yoshioka, T.; Okuwaki, A. Hydrothermal synthesis of needle-like barium sulfate using a barium(ii)-edta chelate precursor and sulfate ions. J. Mater. Sci. Lett. 2000, 19, 1373–1374. [Google Scholar] [CrossRef]
- Uchida, M.; Sue, A.; Yoshioka, T.; Okuwaki, A. Morphology of barium sulfate synthesized with barium(ii)–aminocarboxylate chelating precursors. CrystEngComm 2001, 3, 21–26. [Google Scholar] [CrossRef]
- Jones, F.; Jones, P.; Ogden, M. The interaction of EDTA with barium sulfate. J. Colloid Interface Sci. 2007, 316, 553–561. [Google Scholar] [CrossRef] [PubMed]
- Chen, Q.D.; Shen, X.H. Formation of mesoporous BaSO4 microspheres with a larger pore size via Ostwald Ripening at room temperature. Cryst. Growth Des. 2010, 10, 3838–3842. [Google Scholar] [CrossRef]
- Hua, L.N.; Wang, G.X.; Yang, C. Fabrication of submicron barium sulfate aggregates in the presence of ethylenediaminetetraacetic acid anions. Particuology 2015, 22, 157–162. [Google Scholar] [CrossRef]
- Zhang, M.; Li, X.H.; Hu, Q.Y. Complex synthesis of barium sulfate particles. Chin. J. Nonferrous Met. 2009, 19, 1511–1516. [Google Scholar]
- Zhao, Y.H.; Liu, J.R. Effect of EDTA and phosphate on particle size during precipitation of nanosized BaSO4 particles. Chem. Lett. 2006, 35, 1040–1041. [Google Scholar] [CrossRef]
- Holzwarth, U.; Gibson, N. The Scherrer equation versus the ‘Debye-Scherrer equation’. Nat. Nanotechnol. 2011, 6, 534. [Google Scholar] [CrossRef] [PubMed]
- Piton, D.; Fox, R.O.; Marcant, B. Simulation of fine particle formation by precipitation using computational fluid dynamics. Can. J. Chem. Eng. 2010, 78, 983–993. [Google Scholar] [CrossRef]

| Number | Value (V) | Average Value | Deviation (%) |
|---|---|---|---|
| 1 | 0.3228 | 0.3245 | −0.0017 |
| 2 | 0.3297 | 0.0052 | |
| 3 | 0.3255 | 0.0010 | |
| 4 | 0.3204 | −0.0041 | |
| 5 | 0.3239 | −0.0004 |
| Concentration (mg/dL) | Value |
|---|---|
| 110 | 0.3240 |
| 55 | 0.3773 |
| 27.5 | 0.4248 |
| 13.75 | 0.5037 |
| 6.875 | 0.5968 |
© 2018 by the authors. Licensee MDPI, Basel, Switzerland. This article is an open access article distributed under the terms and conditions of the Creative Commons Attribution (CC BY) license (http://creativecommons.org/licenses/by/4.0/).
Share and Cite
Liu, Y.; Guo, X.; Gu, Q.; He, G.; Yang, S.; Jin, H. Formation and Application of High Reflectivity Controllable Barium Sulfate Microspheres. Crystals 2018, 8, 333. https://doi.org/10.3390/cryst8090333
Liu Y, Guo X, Gu Q, He G, Yang S, Jin H. Formation and Application of High Reflectivity Controllable Barium Sulfate Microspheres. Crystals. 2018; 8(9):333. https://doi.org/10.3390/cryst8090333
Chicago/Turabian StyleLiu, Yuejiao, Xiaoyan Guo, Qingyang Gu, Guangxiang He, Suohe Yang, and Haibo Jin. 2018. "Formation and Application of High Reflectivity Controllable Barium Sulfate Microspheres" Crystals 8, no. 9: 333. https://doi.org/10.3390/cryst8090333
APA StyleLiu, Y., Guo, X., Gu, Q., He, G., Yang, S., & Jin, H. (2018). Formation and Application of High Reflectivity Controllable Barium Sulfate Microspheres. Crystals, 8(9), 333. https://doi.org/10.3390/cryst8090333

